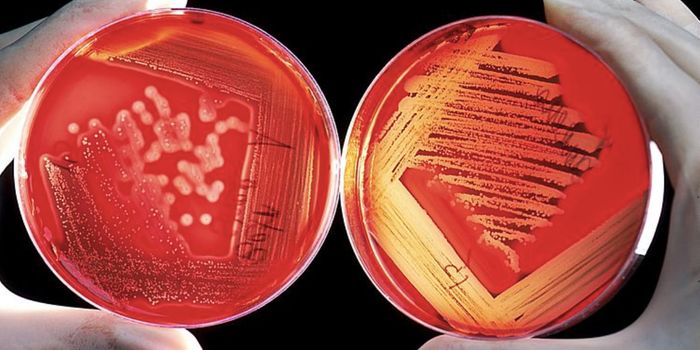
Large Studies Reveal Specific Links Between Depression & Gut Microbes

Preventive care
Preventative care is a type of healthcare focusing on preventing the onset of diseases or identify disease as early as possible when treatment is most feasible. Preventative healthcare can include interventions such as vaccines, screening tests, or regular physical examinations. Effective preventative care will minimize damage caused by illnesses to an individual and can also limit costs associated with medical treatment.
-
FEB 27, 2023CancerA study presented in November at the Society for Immunotherapy of Cancer 37th Annual Meeting and published in the Journa ...Written By: Katie KokolusFEB 17, 2023Chemistry & PhysicsThe bathroom can be a sacred place in one's home. A moment of silence, some privacy, or a place for self-care even. ...Written By: Mandy WoodsFEB 16, 2023Health & MedicineIn the wake of growing health concerns following the train derailment in East Palestine, Ohio, which has resulted in the ...Written By: Christopher DiMaioFEB 13, 2023MicrobiologyAn outbreak of Marburg virus has killed nine people and sickened at least sixteen others in Equatorial Guinea's firs ...Written By: Carmen LeitchFEB 08, 2023Clinical & Molecular DXA study in the American Journal of Preventive Medicine highlighted a spike in verbal assaults directed at public health ...Written By: Kerry CharronFEB 03, 2023Drug Discovery & DevelopmentType 1 Diabetes (T1D) is a autoimmune genetic disease that results in a person’s pancreas not making enough insuli ...Written By: Greta AnneFEB 02, 2023Drug Discovery & DevelopmentThis relative of the six Ebola virus species has no known treatment. Now, a new vaccine is showing promise.Written By: Amielle MorenoJAN 29, 2023NeuroscienceA study published in the Journal of Personality and Social Psychology found that following daily political news can nega ...Written By: Kerry CharronJAN 11, 2023Plants & AnimalsStone tools dated to 50,000 years ago were probably made by capuchin monkeys, not humans.Written By: Brittany Kenyon-FlattJAN 02, 2023MicrobiologyWhile it has gotten competition from SARS-CoV-2, the virus that causes COVID-19, measles is known as one of the most inf ...Written By: Carmen LeitchDEC 12, 2022MicrobiologyTrillions of microbes live in our gastrointestinal tracts, and they exert a powerful influence on various aspects of hum ...Written By: Carmen LeitchDEC 05, 2022Health & MedicineThe gastrointestinal tract is home to trillions of microbes, many of which have a crucial role in our health. Now the US ...Written By: Carmen LeitchNOV 26, 2022Health & MedicineDr. Soumya Swaminathan acknowledged that not calling SARS-CoV-2 airborne "forcefully" earlier in the pandemic was a mist ...Written By: Carmen LeitchNOV 18, 2022Plants & AnimalsLower extremity bypass surgery is a common procedure used to address occluded arteries in the leg, usually with the goal ...Written By: Ryan VingumNOV 11, 2022Health & MedicineThe role of a crucial hormone called INSL3 (insulin-like peptide hormone) has been discovered, and it may help predict w ...Written By: Carmen LeitchNOV 10, 2022MicrobiologyMycobacterium tuberculosis is the pathogenic bacterium that causes TB, which is still a major public health problem in m ...Written By: Carmen LeitchNOV 08, 2022Drug Discovery & DevelopmentTelmisartan, a blood pressure-lowering medication, may help prevent or treat Alzheimer's disease (AD) in Black indiv ...Written By: Annie LennonNOV 03, 2022Drug Discovery & DevelopmentAs COVID-19 and flu virus infection rates are on the rise, another virus is now wreaking havoc on the United States ...Written By: J. Bryce OrtizOCT 31, 2022Plants & AnimalsIn honor of Halloween, from venomous bites to bright red faces to full-moon dances, here are the six weirdest monkeysWritten By: Brittany Kenyon-FlattOCT 30, 2022MicrobiologyThe World Health Organization (WHO) is highlighting the threat posed by fungal pathogens in a new report, which is calli ...Written By: Carmen LeitchOCT 26, 2022Health & MedicineCases of RSV (respiratory syncytial virus), are surging among children. RSV is a common respiratory illness and it norma ...Written By: Carmen LeitchOCT 17, 2022CancerColorectal cancer (CRC) remains the third most common type of cancer diagnosed in men and women in the United States.&nb ...Written By: Katie KokolusOCT 16, 2022NeuroscienceA recent report by the 2022 Lancet Neurology Commission has highlighted the prevalence of traumatic brain injury, which ...Written By: Carmen LeitchOCT 12, 2022CardiologyResearchers have now had years to evaluate the efficacy and safety of COVID-19 vaccines, and the news is good. The mRNA ...Written By: Carmen Leitch
FEB 27, 2023
Cancer
A study presented in November at the Society for Immunotherapy of Cancer 37th Annual Meeting and published in the Journa
...
Written By:
Katie Kokolus
FEB 17, 2023
Chemistry & Physics
The bathroom can be a sacred place in one's home. A moment of silence, some privacy, or a place for self-care even.
...
Written By:
Mandy Woods
FEB 16, 2023
Health & Medicine
In the wake of growing health concerns following the train derailment in East Palestine, Ohio, which has resulted in the
...
Written By:
Christopher DiMaio
FEB 13, 2023
Microbiology
An outbreak of Marburg virus has killed nine people and sickened at least sixteen others in Equatorial Guinea's firs
...
Written By:
Carmen Leitch
FEB 08, 2023
Clinical & Molecular DX
A study in the American Journal of Preventive Medicine highlighted a spike in verbal assaults directed at public health
...
Written By:
Kerry Charron
FEB 03, 2023
Drug Discovery & Development
Type 1 Diabetes (T1D) is a autoimmune genetic disease that results in a person’s pancreas not making enough insuli
...
Written By:
Greta Anne
FEB 02, 2023
Drug Discovery & Development
This relative of the six Ebola virus species has no known treatment. Now, a new vaccine is showing promise.
Written By:
Amielle Moreno
JAN 29, 2023
Neuroscience
A study published in the Journal of Personality and Social Psychology found that following daily political news can nega
...
Written By:
Kerry Charron
JAN 11, 2023
Plants & Animals
Stone tools dated to 50,000 years ago were probably made by capuchin monkeys, not humans.
Written By:
Brittany Kenyon-Flatt
JAN 02, 2023
Microbiology
While it has gotten competition from SARS-CoV-2, the virus that causes COVID-19, measles is known as one of the most inf
...
Written By:
Carmen Leitch
DEC 12, 2022
Microbiology
Trillions of microbes live in our gastrointestinal tracts, and they exert a powerful influence on various aspects of hum
...
Written By:
Carmen Leitch
DEC 05, 2022
Health & Medicine
The gastrointestinal tract is home to trillions of microbes, many of which have a crucial role in our health. Now the US
...
Written By:
Carmen Leitch
NOV 26, 2022
Health & Medicine
Dr. Soumya Swaminathan acknowledged that not calling SARS-CoV-2 airborne "forcefully" earlier in the pandemic was a mist
...
Written By:
Carmen Leitch
NOV 18, 2022
Plants & Animals
Lower extremity bypass surgery is a common procedure used to address occluded arteries in the leg, usually with the goal
...
Written By:
Ryan Vingum
NOV 11, 2022
Health & Medicine
The role of a crucial hormone called INSL3 (insulin-like peptide hormone) has been discovered, and it may help predict w
...
Written By:
Carmen Leitch
NOV 10, 2022
Microbiology
Mycobacterium tuberculosis is the pathogenic bacterium that causes TB, which is still a major public health problem in m
...
Written By:
Carmen Leitch
NOV 08, 2022
Drug Discovery & Development
Telmisartan, a blood pressure-lowering medication, may help prevent or treat Alzheimer's disease (AD) in Black indiv
...
Written By:
Annie Lennon
NOV 03, 2022
Drug Discovery & Development
As COVID-19 and flu virus infection rates are on the rise, another virus is now wreaking havoc on the United States
...
Written By:
J. Bryce Ortiz
OCT 31, 2022
Plants & Animals
In honor of Halloween, from venomous bites to bright red faces to full-moon dances, here are the six weirdest monkeys
Written By:
Brittany Kenyon-Flatt
OCT 30, 2022
Microbiology
The World Health Organization (WHO) is highlighting the threat posed by fungal pathogens in a new report, which is calli
...
Written By:
Carmen Leitch
OCT 26, 2022
Health & Medicine
Cases of RSV (respiratory syncytial virus), are surging among children. RSV is a common respiratory illness and it norma
...
Written By:
Carmen Leitch
OCT 17, 2022
Cancer
Colorectal cancer (CRC) remains the third most common type of cancer diagnosed in men and women in the United States.&nb
...
Written By:
Katie Kokolus
OCT 16, 2022
Neuroscience
A recent report by the 2022 Lancet Neurology Commission has highlighted the prevalence of traumatic brain injury, which
...
Written By:
Carmen Leitch
OCT 12, 2022
Cardiology
Researchers have now had years to evaluate the efficacy and safety of COVID-19 vaccines, and the news is good. The mRNA
...
Written By:
Carmen Leitch